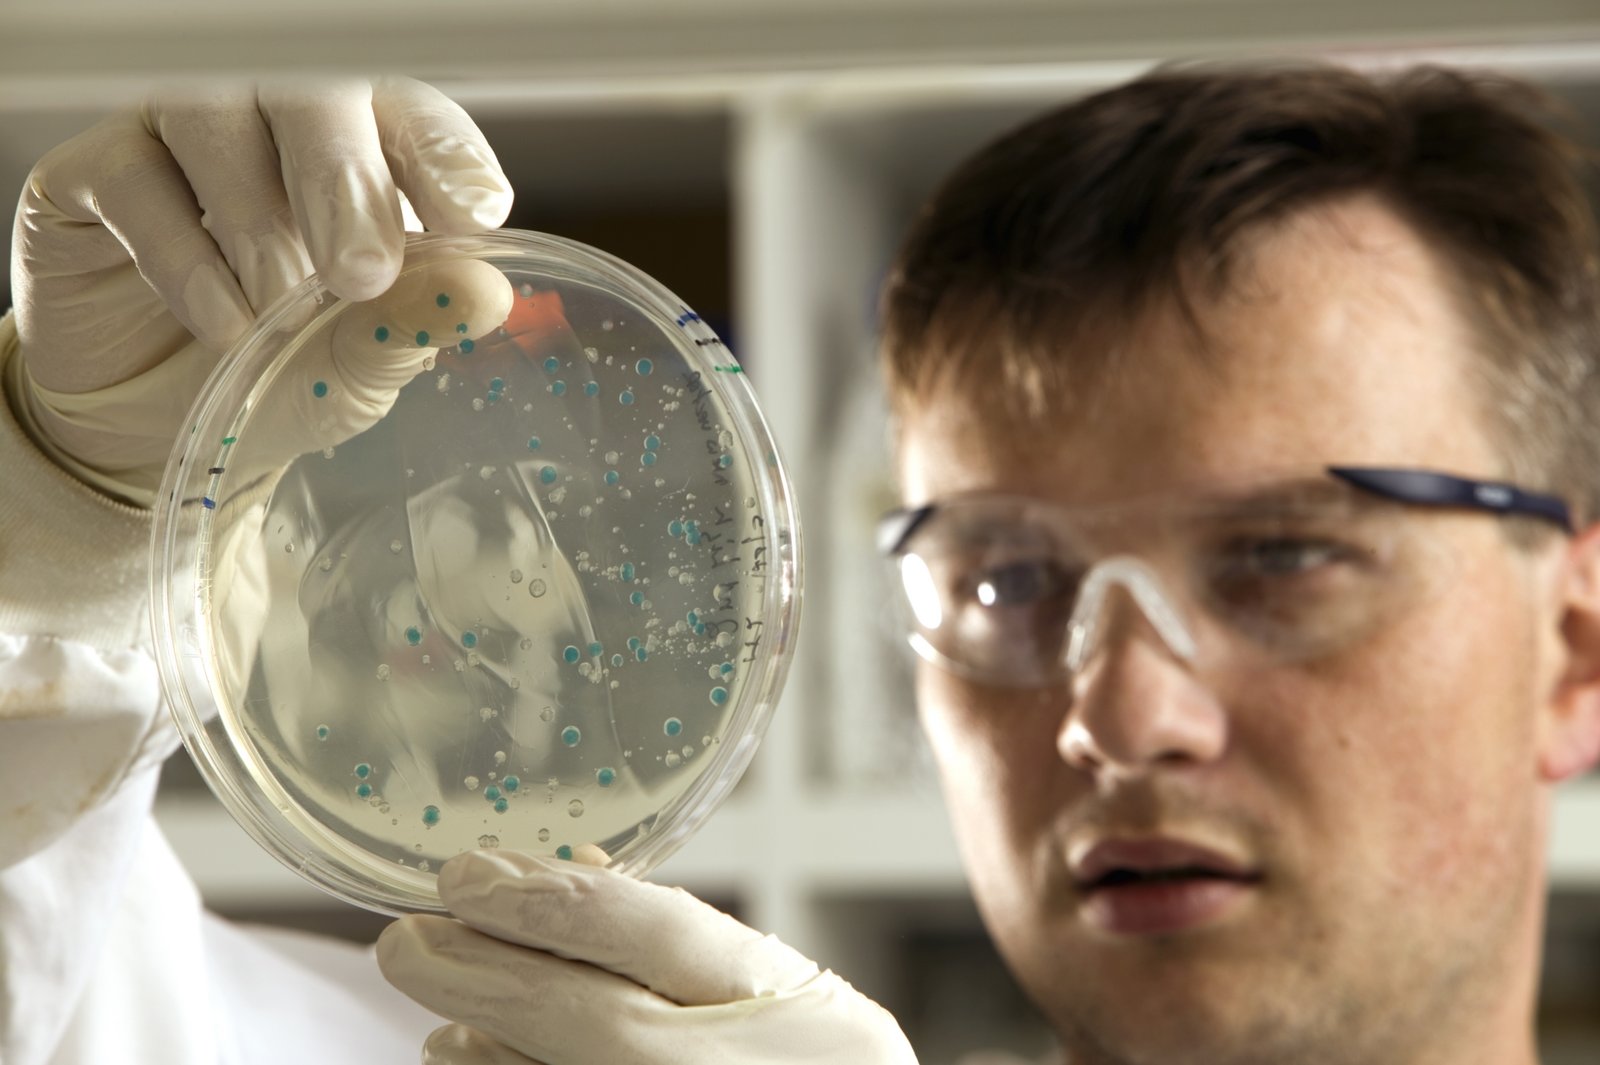
Examining the Impact of Europe's Refugee Crisis on Social Dynamics and National Security

In the summer of 2015, Europe was thrust into one of the largest humanitarian crises of the 21st century – the refugee crisis. As millions of individuals fleeing war, persecution, and poverty sought shelter on European shores, the continent faced a defining moment that would reshape its political, social, and cultural landscape. Now, with the passage of time, it is crucial to critically examine the response and repercussions of the crisis. In this retrospective analysis, we delve into Europe’s handling of the refugee influx, exploring the lessons learned, the challenges encountered, and the lasting impact on the continent. From political turmoil to humanitarian efforts, join us as we reflect on the immense complexities of Europe’s refugee crisis and the far-reaching consequences it continues to unveil.
Table of Contents
- The Multi-faceted Causes that Led Europe to the Brink of a Refugee Crisis
- Examining the Impact of Europe’s Refugee Crisis on Social Dynamics and National Security
- Unearthing the Flaws in Europe’s Response: Lessons Learned and Recommendations for Future Crisis Management
- Empowering Refugees for Long-term Integration: A Necessity Europe Cannot Afford to Overlook
- Q&A
- Concluding Remarks

The Multi-faceted Causes that Led Europe to the Brink of a Refugee Crisis
The European continent, steeped in centuries of history and tradition, is now facing one of its most profound challenges in recent memory. A perfect storm of socio-political upheaval, economic disparity, and regional conflicts has pushed Europe to the brink of a refugee crisis. Behind this wave of migration lies a mosaic of specific events that have shaped the current landscape. From the Arab Spring that ignited revolutions across the Middle East to the devastating civil war in Syria, each thread weaves into a complex tapestry.
One cannot discuss the causes behind this crisis without acknowledging the gripping consequences of ISIS’s rise to power. Their unrelenting brutality and ambition to establish a self-proclaimed Caliphate have plunged entire nations into chaos. Scenes of beheadings, mass executions, and the destruction of ancient cultural heritage sites have sent shockwaves across the globe. The exodus of millions of Syrians fleeing from this violence has overloaded neighboring countries, further compounding the situation. Inevitably, some of these desperate souls have set their sights on Europe as a last hope for survival, placing unprecedented strain on the continent’s fragile political alliances, resources, and social fabric.
Examining the Impact of Europe’s Refugee Crisis on Social Dynamics and National Security
The European refugee crisis, which unfolded with unprecedented magnitude in the mid-2010s, reshaped the continent’s social fabric and posed intricate challenges to national security. One landmark event that underscored the gravity of the situation was the migrant surge in 2015, when over one million asylum seekers arrived in Europe, fleeing conflict and poverty-stricken regions. Desperate to escape their war-torn homelands, families embarked on treacherous journeys across the Mediterranean, often facing perilous conditions and the mercy of human traffickers. The intense humanitarian crisis exposed the vulnerability of the European Union’s border control policies and ignited heated debates across the continent.
This influx of refugees had profound effects on social dynamics, stoking existing tensions and fanning the flames of nationalism. As communities grappled with the sudden influx of foreigners, cultural clashes ensued, sometimes escalating into violence. The rise of far-right movements across Europe capitalized on these concerns, fueling xenophobic sentiments and emphasizing national identity. Simultaneously, the strain on government resources and public services amplifying pre-existing inequalities, further exacerbating social divisions. As a result, the refugee crisis triggered a wave of fear and resentment, forcing societies to confront their values and to question the limits of their humanitarianism.

Unearthing the Flaws in Europe’s Response: Lessons Learned and Recommendations for Future Crisis Management
As the dust settles on the recent crisis that swept through Europe, it is imperative that we reflect on the flaws in the continent’s response and glean lessons for future crisis management. One cannot help but be struck by the sheer magnitude of the challenges faced and the consequences of ineffective decision-making. The events that unfolded laid bare the deep-rooted structural weaknesses in the region’s approach, forcing us to confront uncomfortable truths and embark on a path of course correction.
Firstly, the lack of a unified and coordinated response across Europe greatly impeded the region’s ability to effectively address and contain the crisis. While some countries swiftly implemented stringent measures, others were slow to act, resulting in a disjointed and fragmented approach. The absence of a cohesive strategy allowed the crisis to spread rapidly, leading to devastating human and economic costs. It became abundantly clear that without a coordinated response, the continent stood on shaky ground, undermined by national interests that overshadowed collective well-being.
- Bold and decisive leadership was sorely lacking amidst the chaos, exacerbating the crisis’ impact. Leaders across Europe were caught off guard, scrambling to grasp the severity of the situation. This delay in action proved detrimental, causing irreparable harm to both public health and the economy.
- The overreliance on outdated systems and inadequate infrastructure further aggravated the crisis. Critical sectors such as healthcare and logistics were ill-prepared, unable to handle the surge in demand and strain on resources. The consequences were grim, with hospitals overflowing and supply chains crumbling under immense pressure.
- The failure to effectively communicate and educate the public laid the foundation for fear, misinformation, and hesitancy. Timely and transparent communication is paramount in crisis management, yet this essential element was overshadowed by political bickering and conflicting narratives, leading to confusion and distrust among the population.
Given the harsh lessons learned from this crisis, it is crucial that Europe takes immediate and decisive action to fortify its crisis management capabilities. The formation of a centralized crisis response agency, equipped with the authority to coordinate efforts across member states, is imperative. This agency should operate under a unified framework, ensuring that decision-making is driven by science, expert advice, and the well-being of all Europeans. Furthermore, investment in modernizing critical infrastructure and bolstering healthcare systems must be prioritized to mitigate the devastating impact of future crises. Finally, transparency and open communication channels must be established to foster trust and effectively disseminate vital information to the public.

Empowering Refugees for Long-term Integration: A Necessity Europe Cannot Afford to Overlook
Retrospective Historical Content
In the wake of the unprecedented migrant crisis that roiled Europe in the early 2010s, the continent found itself facing a monumental challenge: how to empower and integrate the influx of refugees in a way that would ensure long-term stability and growth. The crisis, sparked by political unrest, economic instability, and armed conflicts in the Middle East and North Africa, led to a mass exodus of people seeking safety and a chance at a better life in Europe. As countries grappled with the sheer magnitude of the humanitarian emergency, Europe was forced to confront its own limitations and make profound decisions that would shape the future of its social, economic, and political landscape.
The sheer scale of the crisis was staggering. Waves of refugees arrived on the shores of Europe, their desperate journeys filled with unimaginable hardships. It was an exodus reminiscent of historical migrations, evoking images of World War II refugees and the European mass displacement of the late 20th century. Countries strained under the weight of the crisis, their resources stretched thin as they struggled to provide shelter, food, and medical aid to those in need. Stark images of families crammed into overcrowded makeshift camps, children suffering from malnutrition, and the silent despair etched on the faces of those who had lost everything, painted a grim picture of the human cost of conflict.
- Europe grapples with unprecedented migrant crisis
- Political unrest and armed conflicts trigger mass exodus
- Refugees face treacherous journeys and unimaginable hardships
- Countries strained under the weight of the crisis
- Images of overcrowded makeshift camps highlight the human cost of conflict
At the heart of this historic challenge lay the imperative for Europe to not only respond to the immediate crisis but also lay the groundwork for long-term integration of refugees. Failure to do so risked creating a generation lost in limbo, susceptible to years of social exclusion, economic marginalization, and potential radicalization. Europe needed to act, not only out of a moral obligation but also out of self-preservation. This was a defining moment for the continent, a time when its values, resilience, and social cohesion were put to the test. Europe could not afford to overlook the urgent need to empower refugees, to provide them with the tools and opportunities to rebuild their shattered lives, and ultimately contribute to the fabric of their host societies.
The challenges ahead were immense, but Europe had proved time and again that it possessed the ability to rise above adversity and find innovative solutions to complex problems. By harnessing its collective will and leveraging the power of solidarity, Europe had the potential to turn the refugee crisis into an opportunity for growth, diversity, and integration. It was a historical moment that called for bold action, visionary leadership, and a reassessment of policies and programs. As the continent embarked on this daunting journey, the world watched with bated breath, holding out hope that Europe would rise to the occasion and create a brighter future for its newest residents.
- Long-term integration crucial to prevent social exclusion and radicalization
- Europe faced a defining moment that tested its values and resilience
- The refugee crisis presented an opportunity for growth, diversity, and integration
- Europe embarked on a journey of reassessing its policies and programs
- The world looked on with hope for a brighter future
In Summary
In conclusion, as we reflect on the tumultuous years of Europe’s refugee crisis, it becomes evident that it was a watershed moment, profoundly reshaping the continent’s political landscape and moral compass. Our retrospective analysis has delved deep into the complexities and nuances of this complex issue, shedding light on the successes, failures, and lessons learned.
Amidst the unprecedented wave of asylum seekers, Europe’s response was a test of its values, compassion, and resilience. Through this retrospective, we have witnessed the immense challenges faced by nations grappling with the influx of displaced individuals, forced to confront logistical, social, and economic obstacles on an unprecedented scale.
While Europe demonstrated commendable solidarity in some instances, opening its borders and providing refuge to those in need, there were also moments of division, exposing deep-seated tensions among member states. These divisions served as stark reminders of the complex web of political dynamics, historical grievances, and economic disparities that exist among nations within the European Union.
Moreover, our analysis highlighted the immense strains placed on the infrastructure and resources of host countries. From overcrowded reception centers to the strain on educational systems, healthcare, and housing, this crisis revealed the pressing need for robust international cooperation and sustainable solutions to effectively address the ever-growing humanitarian challenges.
Yet, amidst the challenges, there were stories of resilience, hope, and unity that emerged from the crisis. Communities and individuals across Europe rallied together, offering support, protection, and understanding to the displaced. These acts of kindness, compassion, and solidarity reminded us of the enduring human spirit and the power of empathy in the face of adversity.
As we conclude this retrospective analysis, it is crucial to acknowledge that while significant progress has been made, the refugee crisis is far from resolved. It demands ongoing dedication to finding comprehensive, long-term solutions that address the root causes of displacement, improve access to education and healthcare, and foster integration and social cohesion for both refugees and host communities.
Moving forward, Europe must commit to leveraging its shared values and collective strengths to develop a unified approach that transcends national interests and works towards a sustainable, fair, and compassionate response to future challenges. By learning from past mistakes and embracing the wealth of experiences gained throughout this crisis, Europe can forge a better, more inclusive future for all its inhabitants.
As we bid farewell to this retrospective, it is our hope that this analysis will serve as a catalyst for thoughtful discussions, informed decision-making, and, most importantly, tangible action. Only through collective efforts, empathy, and a commitment to shared humanity can Europe truly rise above its refugee crisis and build a future that upholds its noble ideals.
